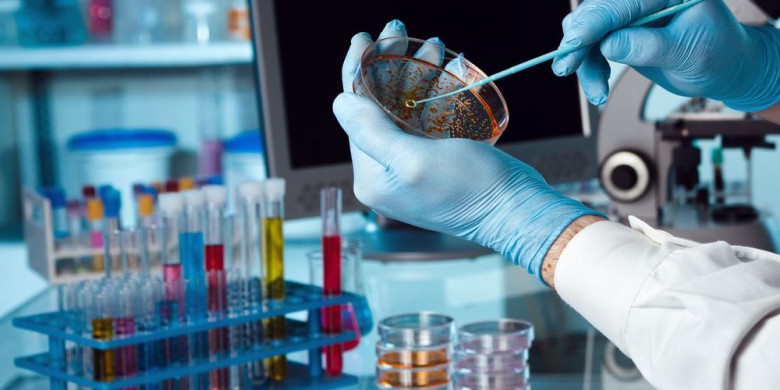

Ερευνητές βρήκαν έναν νέο τρόπο να δημιουργούν σε τρισδιάστατη μορφή ζωντανό δέρμα, συμπεριλαμβανομένων των αιμοφόρων αγγείων του.
Η εξέλιξη αυτή, που δημοσιεύτηκε στην επιστημονική επιθεώρηση «Tissue Engineering Part A», συνιστά σημαντικό βήμα για τη δημιουργία μοσχευμάτων τα οποία είναι παρόμοια με το δέρμα που ο οργανισμός παράγει φυσικά και είναι επομένως λιγότερο πιθανό να απορριφθούν από τον οργανισμό.
Τα εμπόδια μέχρι σήμερα
Ο Πανκάι Καράντε, αναπληρωτής καθηγητής χημικής και βιολογικής μηχανικής και μέλος του Κέντρου Βιοτεχνολογίας και Διεπιστημονικών Ερευνών στη Νέα Υόρκη, εξηγεί ότι τα μοσχεύματα που υπήρχαν μέχρι σήμερα θα μπορούσαν να προσομοιαστούν με ένα είδος χανζαπλάστ καθώς συμβάλλουν μεν στην γρηγορότερη επούλωση μιας πληγής αλλά εντέλει δεν γίνονται ποτέ πλήρως μέρος του κυττάρου ξενιστή, με αποτέλεσμα να πέφτουν έπειτα από λίγο καιρό.
Το εμπόδιο αυτό οφειλόταν στο ότι στα μέχρι τώρα μοσχεύματα δεν υπήρχε λειτουργικό αγγειακό σύστημα που να τα συγκρατεί.
Στην συγκεκριμένη μελέτη, οι ερευνητές έδειξαν ότι, αν συνδύαζαν βασικά στοιχεία – συμπεριλαμβανομένων των ενδοθηλιακών κυττάρων και των περικυττάρων (σ.τ.σ: Τα περιαγγειακά κύτταρα ή περικύτταρα είναι αγγειακά μυϊκά κύτταρα που καλύπτουν την επιφάνεια των αγγείων και εισφέρουν στην ακεραιότητα και σταθερότητα του αγγειακού αυλού. Δραστηριοποιούνται λειτουργικά στο σχηματισμό νεόπλαστων αγγείων και, επομένως, παριστούν δυνητικούς στόχους αντινεοπλασματικών θεραπειών) με ζωικό κολλαγόνο και άλλα δομικά κύτταρα που συνήθως βρίσκουμε σε μοσχεύματα δέρματος, τα κύτταρα ξεκινούν να επικοινωνούν και να διαμορφώνουν βιολογικά σχετικές αγγειακές δομές με αυτές που δημιουργεί από μόνο του το δέρμα μέσα σε μερικές εβδομάδες.
Επικοινωνία του μοσχεύματος με το δέρμα
Όταν η ερευνητική ομάδα του Γέιλ έκανε μεταμόσχευση σε έναν συγκεκριμένο τύπο ποντικιού, τα αγγεία από το δέρμα που δημιουργήθηκε σε τρισδιάστατη μορφή από τους ερευνητές του Πολυτεχνικού Ινστιτούτου Ρενσίλιαρ ξεκίνησε να επικοινωνεί και να συνδέεται με τα αγγεία του ίδιου του ποντικιού.
«Αυτό είναι πραγματικά σημαντικό, επειδή γνωρίζουμε ότι στην πραγματικότητα υπάρχει μια μεταφορά αίματος και θρεπτικών συστατικών στο μόσχευμα που το βοηθούν να μείνει ζωντανό» είπε ο Καραντε.
Προκειμένου να κάνουν αυτό το εύρημα χρήσιμο σε κλινικό επίπεδο, οι ερευνητές πρέπει να μπορούν να επεξεργαστούν τα κύτταρα του δότη χρησιμοποιώντας μια τεχνολογία παρόμοια με τη γονιδιωματική τροποποίηση (CRISPR), ώστε τα αγγεία να μπορούν να εισέλθουν και να γίνουν αποδεκτά από το σώμα του ασθενή.
Σημαντικό για ασθενείς με διαβήτη ή έλκη
Αλλά τα μοσχεύματα που δημιούργησε αυτή η ερευνητική ομάδα φέρνουν τους επιστήμονες πιο κοντά στο να μπορέσουν να βοηθήσουν ανθρώπους με διακριτές ιατρικές καταστάσεις, όπως διαβήτη και έλκη.
Για τους ασθενείς αυτούς η εξέλιξη αυτή έχει μεγάλη σημασία διότι τα έλκη συνήθως εμφανίζονται σε ευδιάκριτα μέρη του σώματος και μπορούν να αντιμετωπιστούν με μικρότερα κομμάτια μοσχευμάτων δέρματος, είπε ο Καράντε.
Η επούλωση πληγών απαιτεί περισσότερο χρόνο στους ασθενείς με διαβήτη και επομένως τα νέα μοσχεύματα μπορεί επίσης να βοηθήσουν στην επιτάχυνση αυτής της διαδικασίας.
Πηγή: ΑΠΕ-ΜΠΕ